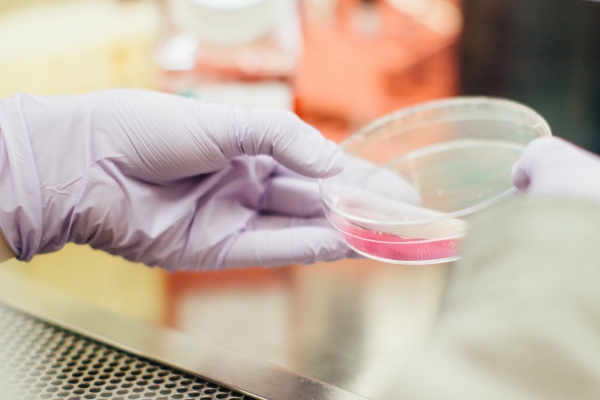

This month's healthcare newsletter brings you the latest in updates from Korea's fast-paced biopharma landscape, including notable changes to the public health insurance system - shifting Korea's co-pay model to one with fixed rates - and a second-stage pharmacogenetics initiative to bolster availability of local population test data.
Please refer to the attached document for detailed insights.
| Attachment | Size |
|---|---|
| Systematic healthcare reform_A new fixed_rate system and committee_July 2024 | 426.71 KB |